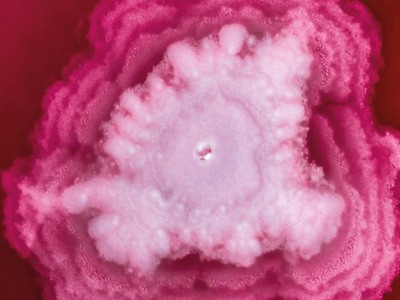

Hittar du dig själv i vimlet?

En blick genom mikroskopet och nya frågor väcks direkt.

Kroppen som klurigt pussel, var sitter egentligen allt?

Teknikstrul? Inte här. Barnen tog snacket med robotarna utan problem.

Fullt fokus i trampbilsverkstaden.

Full fart framåt! Inga motorer behövs när benen gör jobbet.

Ett härligt vimmel när 500 besökare utforskade alla aktiviteter under Campuskalaset.

Schlagerstämning i fotobåset!

När teori blir något som säger blubb, blubb.

Måleripaus mitt i allt annat som hände på kalaset.









Ansiktsmålning, experiment och byggstationer runtom på campus fick både barn och vuxna att testa, utforska och skapa på sina egna sätt. Några drogs till labben, andra stannade länge i verkstadsdelen eller fastnade i digitala världar. I biblioteket fanns plats för en paus och en stunds nyfiken läsning.
Tack till alla som klev in i vår värld av mikroskop, robotar, kartongbyggen och trampbilar. Campuskalaset blev inte en dag om forskning, utan en dag då den kändes i kroppen. Extra fint i år när Skövde utsetts till Årets studentstad.
Vad är Campuskalaset?
Den 10-15 november bjöd vi in allmänheten till en vecka fylld av spännande föreläsningar, kunskap, upplevelser och inspiration.
Gick du vår tipspromenad?
Gick du vår tipspromenad och klurar nu febrilt på hur det gick? Nu behöver du inte hålla dig längre, här nedanför hittar du alla rätta svar! Scrolla vidare och se om du briljerade, blev lurad av någon klurig fråga eller kanske har en revansch att ta nästa gång.
Vi hör av oss personligen till tre vinnare. Tack till alla er som deltog och bidrog till en riktigt lyckad tipspromenad!
De rätta svaren på tipspromenaden
-
Rätt svar: Alla som är nyfikna och tycker om att samarbeta.
Läs mer om våra ingenjörsutbildningar. -
Rätt svar: Robotar som spelpartner och spelledare för äldre personer.
Vill du veta mer? Läs artikeln Robotar ska göra livet roligare för äldre personer. -
Rätt svar: Anpassningar vid examinationer
Om du är intresserad av att studera hos oss och har en funktionsnedsättning, vill vi gärna att du ska känna dig trygg med att det finns stöd att få. Ta gärna en titt på sidan Studera med funktionsnedsättning.
-
Rätt svar: Högskolan fyller 50 år.
Vi arbetar för att vara den självklara kunskapskällan för en digitaliserad och hållbar framtid. Om du vill läsa mer om hur vi tänker och planerar framåt kan du läsa mer på sidan Utvecklingsplan för Högskolan i Skövde.
-
Rätt svar: Ett kafé med alkoholservering
Läs mer om Kårhuset Boulogner. -
Rätt svar: Game Writing
Vill du levla upp dina kunskaper om Game Writing? Spana in sidan Dataspelsutveckling - Game Writing. -
Rätt svar: 2008
Läs mer om varför Skövde har fått den fina utmärkelsen Årets studentstad. -
Rätt svar: Aktiebolag
Nailade du frågan snabbare än någon hann säga ”bokföringsunderlag”, då är en ekonomiutbildning kanske din grej? Surfa till utbildningarna på sidan Ekonomi.
-
Rätt svar: En minut
Häftigt hur snabbt blodet rör sig, eller hur? Men när kroppen överreagerar på en infektion kan det gå fort åt fel håll. På Högskolan i Skövde har vi gjort stora forskningsframsteg för att identifiera sepsis tidigt och därigenom rädda fler liv. Läs mer om vår forskning inom sepsis. -
Rätt svar: August Strindberg
Strindberg fick inget Nobelpris men om du tänker ro hem ett i framtiden lär du knappast komma runt biblioteket. Läs mer om vårt Högskolebibliotek.
-
Rätt svar: En leksaksbutik
Nyfikenhet börjar ofta i leken. Hos oss fortsätter den i teknik, spel och innovation. Se våra utbildningar.
-
Rätt svar: 64 800 stycken
64 800 böcker! Om du börjar läsa nu är du klar… någon gång på 2300-talet. Och då är du väl rustad för tipspromenader som den här.